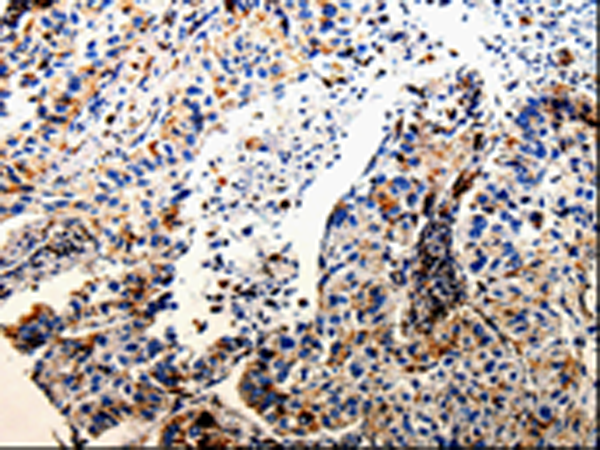

|
Background: |
The protein encoded by this gene is a lysosomal cysteine proteinase and member of the peptidase C1 family. It exhibits both carboxy-monopeptidase and carboxy-dipeptidase activities. The encoded protein has also been known as cathepsin X and cathepsin P. This gene is expressed ubiquitously in cancer cell lines and primary tumors and, like other members of this family, may be involved in tumorigenesis. |
|
Applications: |
ELISA, WB, IHC |
|
Name of antibody: |
CTSZ |
|
Immunogen: |
Fusion protein of human CTSZ |
|
Full name: |
Cathepsin Z |
|
Synonyms: |
CTSX |
|
SwissProt: |
Q9UBR2 |
|
ELISA Recommended dilution: |
500-2000 |
|
IHC positive control: |
Human lung cancer |
|
IHC Recommend dilution: |
10-50 |
|
WB Predicted band size: |
34 kDa |
|
WB Positive control: |
Hela cells |
|
WB Recommended dilution: |
500-1000 |

購物車
購物車 幫助
幫助
 021-54845833/15800441009
021-54845833/15800441009
